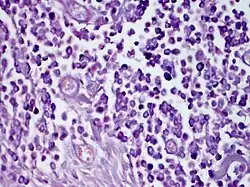

Solitary mastocytoma
| Solitary mastocytoma | |
|---|---|
| Other names | Cutaneous mastocytoma |
| |
| Solitary mastocytoma. | |
| Specialty | Dermatology, oncology |
Solitary mastocytoma, also known as cutaneous mastocytoma, may be present at birth or may develop during the first weeks of life, originating as a brown macule that urticates on stroking.[1]: 615 Solitary mastocytoma is a round, erythematous, indurated lesion measuring 1-5 cm in diameter. It can be mildly itchy or asymptomatic and develops over time. Predilection is the head and neck, followed by the trunk, extremities, and flexural areas.
About 40% of children with cutaneous mastocytosis have exon 17 KIT mutations, while 40% have other exon mutations. Stem cell factor expression is increased in some cases, and solitary cutaneous mastocytomas have been reported at trauma sites.
The diagnosis of solitary mastocytoma is primarily clinical, with skin biopsy confirming a KIT mutation and mast cell infiltration. Treatments are symptomatic, with oral H1 antihistamines being the mainstay. Preventative measures include air conditioning, lukewarm water, and avoiding triggers.
Signs and symptoms
Solitary mastocytoma usually presents as an indurated, erythematous, round or oval, yellow-brown or reddish-brown, papule, plaque, or nodule, typically measuring 1 to 5 cm in diameter.[2] The lesion frequently has a leathery or rubbery nature and a peau d'orange (pebbly, orange peel-like) appearance.[3] The margins of the lesions may be sharp or vague.[4] The degree of pruritus varies; a lesion may be mildly itchy or asymptomatic.[5] It normally develops larger for a few months, then for a variable amount of time grows in accordance to the patients size before gradually shrinking.[3] The head and neck are the sites of predilection, followed by the trunk, extremities, and flexural areas.[6] Usually, the soles and palms are unaffected.[7]
The lesion may urticate on its own initiative or, more frequently, in response to being stroked or rubbed. The lesion becomes itchy, erythematous, or edematous when touched or rubbed; this reaction is known as the Darier sign.[3][8] The phenomenon is regarded as pathognomonic since it is brought on by the release of mast cell mediators in response to physical stimulus.[9] The diagnosis of mastocytosis is not ruled out in the absence of a positive Darier sign because it is evoked in only around 50% and 90% of patients with solitary mastocytoma and other kinds of cutaneous mastocytosis, respectively.[10][11] Certain lesions may erupt in painful blisters.[4][12]
Patients with solitary cutaneous mastocytosis may also experience systemic symptoms, however they are far more common in those with systemic mastocytosis. These symptoms include flushing, dyspnea, hypotension, nausea, vomiting, abdominal discomfort, diarrhea, and headaches.[8][13]
Causes
Exon 17 KIT mutations are present in about 40% of children with cutaneous mastocytosis, while KIT mutations outside of exon 17 (such as exon 8, 9, 10, 11) are present in another 40% of children, and no KIT mutations are present in the other children.[4][14] Increased expression of stem cell factor has been observed in certain children with cutaneous mastocytosis, and stem cell factor plays a crucial role in mast cell development.[2] There have been reports of solitary cutaneous mastocytomas developing at trauma sites, like immunization sites.[15][16]
Mechanism
It has been demonstrated that in solitary cutaneous mastocytomas, melanocyte stimulation results in elevated local concentrations of soluble mast cell growth factors.[17][18] Melanin pigment is produced locally as a result of melanocyte proliferation. This explains why the lesion in a solitary cutaneous mastocytoma appears hyperpigmented.[8]
Diagnosis
Based on the lesion's shape, the existence of a positive Darier sign, and the lack of systemic involvement, the diagnosis is primarily clinical.[19] If necessary, a skin biopsy can be used to confirm the diagnosis by demonstrating a KIT mutation in the lesional skin and confirming mast cell infiltration in the dermis.[2]
Treatment
Most treatments are symptomatic.[2] For the most part, reassurance and avoiding triggers are sufficient.[20][21] The mainstay of treatment for pruritus and flushing is oral H1 antihistamines. Oral H2 antihistamines may be used for further benefit in severe situations.[2] In patients with gastrointestinal symptoms (heartburn, abdominal discomfort, bloating, diarrhea) related to solitary cutaneous mastocytoma, oral H2 antihistamines, either with or without oral cromoglycate, should be investigated.[20] Using air conditioning in hot weather, bathing in lukewarm water, and removing or avoiding triggers are examples of preventative methods.[22]
See also
References
- ^ James, William; Berger, Timothy; Elston, Dirk (2005). Andrews' Diseases of the Skin: Clinical Dermatology. (10th ed.). Saunders. ISBN 0-7216-2921-0.
- ^ a b c d e Leung, Alexander K. C.; Lam, Joseph M.; Leong, Kin Fon (2019-04-05). "Childhood Solitary Cutaneous Mastocytoma: Clinical Manifestations, Diagnosis, Evaluation, and Management". Current Pediatric Reviews. 15 (1). Bentham Science Publishers Ltd.: 42–46. doi:10.2174/1573396315666181120163952. ISSN 1573-3963. PMC 6696819. PMID 30465511.
- ^ a b c Gori, Abdulla; Torneria, Carlos; Kelly, Victoria M.; Zlotoff, Barrett J.; Contreras, Michael E. (2009-07-01). "Visual Diagnosis". Pediatrics in Review. 30 (7). American Academy of Pediatrics (AAP): 280–283. doi:10.1542/pir.30.7.280. ISSN 0191-9601. PMID 19570927.
- ^ a b c Hartmann, Karin; Escribano, Luis; Grattan, Clive; Brockow, Knut; Carter, Melody C.; Alvarez-Twose, Ivan; Matito, Almudena; Broesby-Olsen, Sigurd; Siebenhaar, Frank; Lange, Magdalena; Niedoszytko, Marek; Castells, Mariana; Oude Elberink, Joanna N.G.; Bonadonna, Patrizia; Zanotti, Roberta; Hornick, Jason L.; Torrelo, Antonio; Grabbe, Jürgen; Rabenhorst, Anja; Nedoszytko, Boguslaw; Butterfield, Joseph H.; Gotlib, Jason; Reiter, Andreas; Radia, Deepti; Hermine, Olivier; Sotlar, Karl; George, Tracy I.; Kristensen, Thomas K.; Kluin-Nelemans, Hanneke C.; Yavuz, Selim; Hägglund, Hans; Sperr, Wolfgang R.; Schwartz, Lawrence B.; Triggiani, Massimo; Maurer, Marcus; Nilsson, Gunnar; Horny, Hans-Peter; Arock, Michel; Orfao, Alberto; Metcalfe, Dean D.; Akin, Cem; Valent, Peter (2016). "Cutaneous manifestations in patients with mastocytosis: Consensus report of the European Competence Network on Mastocytosis; the American Academy of Allergy, Asthma & Immunology; and the European Academy of Allergology and Clinical Immunology". Journal of Allergy and Clinical Immunology. 137 (1). Elsevier BV: 35–45. doi:10.1016/j.jaci.2015.08.034. ISSN 0091-6749. PMID 26476479.
- ^ Puri, Poonam; Singh, Avninder; Ramesh, V; Gopal, Dhruv (2014). "Asymptomatic solitary cutaneous mastocytoma: A rare presentation". Indian Journal of Dermatology. 59 (6). Medknow: 634. doi:10.4103/0019-5154.143588. ISSN 0019-5154. PMC 4248540. PMID 25484432.
- ^ Briley, Laura D.; Phillips, Charles M. (2008). "Cutaneous Mastocytosis: A Review Focusing on the Pediatric Population". Clinical Pediatrics. 47 (8). SAGE Publications: 757–761. doi:10.1177/0009922808318344. ISSN 0009-9228. PMID 18502981.
- ^ Janakiramanan, N.; Chambers, D.; Dowling, G.J. (2010). "A rare presentation of solitary mastocytoma in the palm of an infant". Journal of Plastic, Reconstructive & Aesthetic Surgery. 63 (2). Elsevier BV: e197 – e198. doi:10.1016/j.bjps.2009.02.061. ISSN 1748-6815. PMID 19502121.
- ^ a b c Bulat, Vedrana; Mihić, Liborija Lugović; Situm, Mirna; Buljan, Marija; Blajić, Iva; Pusić, Jana (2009). "Most common clinical presentations of cutaneous mastocytosis". Acta Clinica Croatica. 48 (1): 59–64. ISSN 0353-9466. PMID 19623875.
- ^ De Giorgi, Vincenzo; Fabroni, Caterina; Alfaioli, Barbara; Massi, Daniela; Maio, Vincenza; Sestini, Serena; Papi, Federica; Gori, Alessia; Lotti, Torello (2008-11-25). "Solitary mastocytoma: tooth eruption as triggering factor". International Journal of Dermatology. 47 (12). Wiley: 1274–1277. doi:10.1111/j.1365-4632.2008.03841.x. ISSN 0011-9059. PMID 19126015.
- ^ Krishnan, Karthik R.; Ownby, Dennis R. (2010-11-01). "A solitary mastocytoma presenting with urticaria and angioedema in a 14-year-old boy". Allergy and Asthma Proceedings. 31 (6). Oceanside Publications Inc.: 520–523. doi:10.2500/aap.2010.31.3368. ISSN 1088-5412. PMID 21708063.
- ^ Conrad, Heather; Gausche-Hill, Marianne; Burbulys, David (2007). "A 6-Month Old With Total Body Flushing and a Macular-Papular Lesion". Pediatric Emergency Care. 23 (5). Ovid Technologies (Wolters Kluwer Health): 321–323. doi:10.1097/01.pec.0000270165.85862.12. ISSN 0749-5161. PMID 17505276.
- ^ Singal, A; Aggarwal, S; Pandhi, D (2008). "Adult onset, hypopigmented solitary mastocytoma: Report of two cases". Indian Journal of Dermatology, Venereology and Leprology. 74 (1). Scientific Scholar: 41–43. doi:10.4103/0378-6323.38407. hdl:1807/48039. ISSN 0378-6323. PMID 18187823.
- ^ Exposito-Serrano, Vicente; Agut-Busquet, Eugenia; Leal Canosa, Lorena; Herrerías Moreno, Jose; Saez, Amparo; Luelmo, Jesús (2017-12-11). "Pleomorphic mastocytoma in an adult". Journal of Cutaneous Pathology. 45 (2). Wiley: 176–179. doi:10.1111/cup.13080. ISSN 0303-6987. PMID 29148588.
- ^ Wiechers, Tim; Rabenhorst, Anja; Schick, Tina; Preussner, Liane M.; Förster, Anja; Valent, Peter; Horny, Hans-Peter; Sotlar, Karl; Hartmann, Karin (2015). "Large maculopapular cutaneous lesions are associated with favorable outcome in childhood-onset mastocytosis". Journal of Allergy and Clinical Immunology. 136 (6). Elsevier BV: 1581–1590.e3. doi:10.1016/j.jaci.2015.05.034. ISSN 0091-6749. PMID 26152315.
- ^ Koh, Mark Jean Aan; Chong, Wei Sheng (2008). "Red Plaque After Hepatitis B Vaccination". Pediatric Dermatology. 25 (3). Wiley: 381–382. doi:10.1111/j.1525-1470.2008.00710.x. ISSN 0736-8046. PMID 18577051.
- ^ Tuxen, Alana Jane; Orchard, David (2009-04-23). "Solitary mastocytoma occurring at a site of trauma". Australasian Journal of Dermatology. 50 (2). Wiley: 133–135. doi:10.1111/j.1440-0960.2009.00526.x. ISSN 0004-8380. PMID 19397569.
- ^ Okun, M. R. (1982). "Mast cells, melanocytes, balloon cells". The American Journal of Dermatopathology. 4 (5): 478–479. doi:10.1097/00000372-198210000-00019. ISSN 0193-1091. PMID 7149204.
- ^ Cohen, Philip R. (2016-07-31). "Solitary mastocytoma presenting in an adult: report and literature review of adult-onset solitary cutaneous mastocytoma with recommendations for evaluation and treatment". Dermatology Practical & Conceptual. 6 (3). Mattioli1885: 31–38. doi:10.5826/dpc.0603a07. ISSN 2160-9381. PMC 5006550. PMID 27648381.
- ^ Azaña, J.M.; Torrelo, A.; Matito, A. (2016). "Actualización en mastocitosis. Parte 1: fisiopatología, clínica y diagnóstico". Actas Dermo-Sifiliográficas (in Spanish). 107 (1). Elsevier BV: 5–14. doi:10.1016/j.ad.2015.09.007. ISSN 0001-7310.
- ^ a b Klaiber, Nicholas; Kumar, Santhosh; Irani, Anne-Marie (2017-10-07). "Mastocytosis in Children". Current Allergy and Asthma Reports. 17 (11). Springer Science and Business Media LLC. doi:10.1007/s11882-017-0748-4. ISSN 1529-7322.
- ^ Sonthalia, Sidharth; Nair, Brijesh; Aggarwal, Ishad (2016). "Solitary mastocytoma with positive Darier′s sign". Indian Dermatology Online Journal. 7 (2). Medknow: 141–142. doi:10.4103/2229-5178.178091. ISSN 2229-5178. PMC 4804594. PMID 27057508.
- ^ Chantorn, Rattanavalai; Shwayder, Tor (2012-02-14). "Death from Mast Cell Leukemia: A Young Patient with Longstanding Cutaneous Mastocytosis Evolving into Fatal Mast Cell Leukemia". Pediatric Dermatology. 29 (5). Wiley: 605–609. doi:10.1111/j.1525-1470.2011.01650.x. ISSN 0736-8046. PMID 22329485.
Further reading
- McKinnon, Elizabeth L.; Rand, Andrew J.; Proia, Alan D. (2018). "Solitary mastocytoma in the eyelid of an adult". American Journal of Ophthalmology Case Reports. 9. Elsevier BV: 103–105. doi:10.1016/j.ajoc.2018.01.009. ISSN 2451-9936. PMC 5787878. PMID 29468227.
- Khan, Kelly; Kupferman, Michael E.; Gardner, Jerad M.; Ivan, Doina (2011). "Solitary mastocytoma in an adult with an unusual clinical presentation". Journal of the American Academy of Dermatology. 65 (3): 683–684. doi:10.1016/j.jaad.2010.08.013. PMID 21839341.